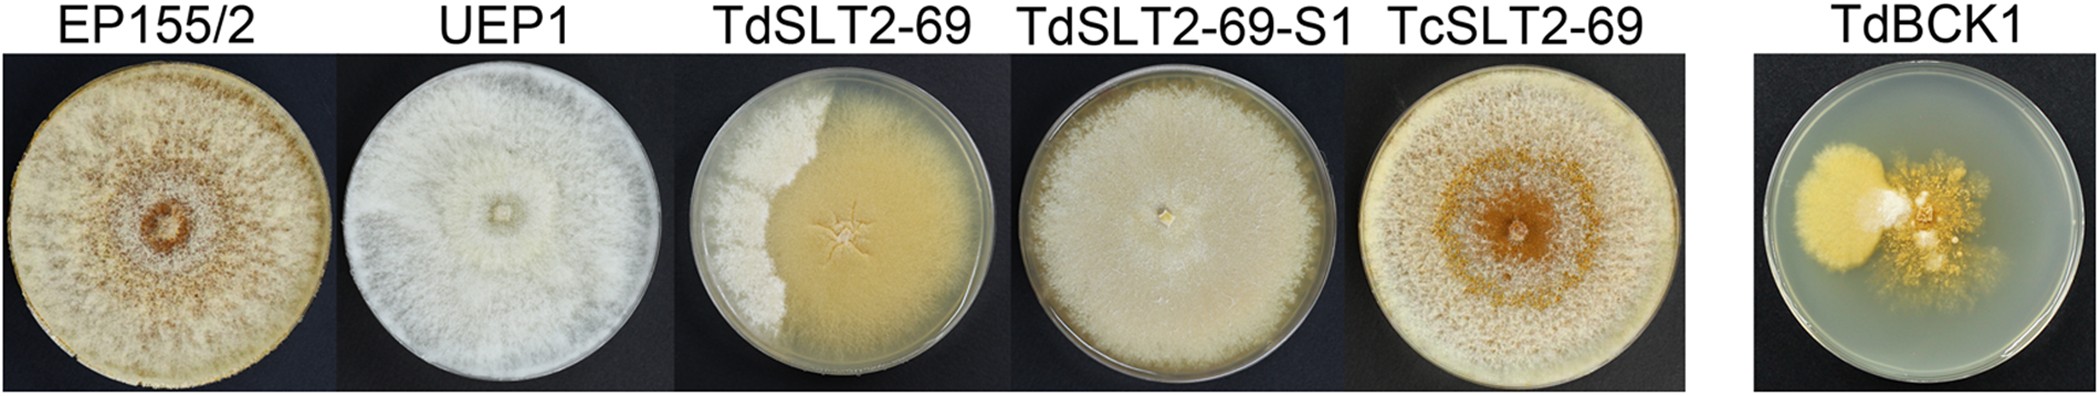
Figure 1

Figure 1
Colony morphology of the CpSlt2-null mutant (TdSLT2-69) strain. Strains, as indicated on the panels, are wild-type EP155/2, hypovirulent UEP1, TdSLT2-69, a sectored progeny of TdSLT2-69 (TdSLT2-69-S1), a complemented strain of TdSLT2-69 (TcSLT2-69), and the CpBck1-null mutant (TdBCK1) strain. Colonies after 14 d of culture are shown. Note that TdSLT2-69 colonies show the sectored phenotype. The CpBck1-null mutant (TdBCK1) (i.e., a mutant strain of MAPKKK in the same CWI pathway) is shown as a comparison.